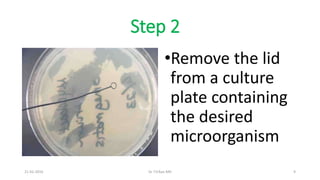
Step 2
•Remove the lid
from a culture
plate containing
the desired
microorganism
21-02-2016 Dr T.V.Rao MD 9
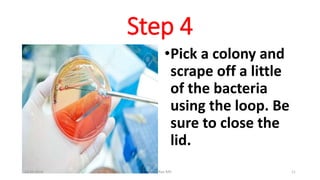
Step 4
•Pick a colony and
scrape off a little
of the bacteria
using the loop. Be
sure to close the
lid.
21-02-2016 Dr T.V.Rao MD 11
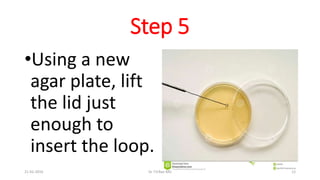
Step 5
•Using a new
agar plate, lift
the lid just
enough to
insert the loop.
21-02-2016 Dr T.V.Rao MD 12
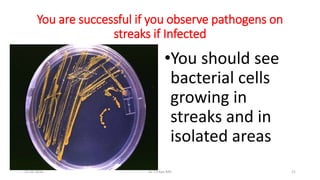
You are successful if you observe pathogens on
streaks if Infected
•You should see
bacterial cells
growing in
streaks and in
isolated areas
21-02-2016 Dr T.V.Rao MD 21

This document provides instructions for streaking bacteria on a petri dish. It describes the history and purpose of petri dishes, which are used to culture microorganisms while separating them from airborne contaminants. The document then outlines the 9 step process for streaking bacteria on an agar plate, which involves sterilizing an inoculating loop, transferring bacteria in a zigzag pattern, rotating the plate and repeating to isolate individual colonies. The plates are incubated upside down overnight to allow the bacteria to grow.